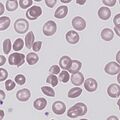
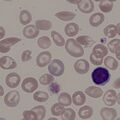
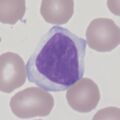
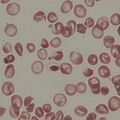
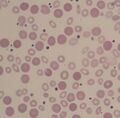
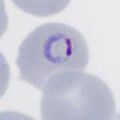
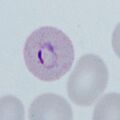
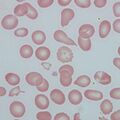

Uncategorised files
Showing below up to 50 results in range #51 to #100.
- Boat2.jpg 472 × 472; 36 KB
- Boat2A.png 454 × 454; 79 KB
- Boat3.jpg 472 × 472; 46 KB
- Boat4.jpg 472 × 472; 53 KB
- Boat5.jpg 591 × 591; 63 KB
- CD45-PopA.jpg 315 × 315; 29 KB
- CD45-PopB.jpg 315 × 315; 42 KB
- CD45-PopB.png 591 × 472; 233 KB
- CD45-PopC.jpg 315 × 315; 39 KB
- CD45-PopD.jpg 315 × 315; 36 KB
- CD45-PopE.jpg 315 × 315; 49 KB
- CD45 populations.jpg 315 × 315; 59 KB
- CD45 populations.png 1,119 × 1,074; 427 KB
- CLL.jpg 236 × 236; 24 KB
- CLLCD45.jpg 394 × 270; 83 KB
- Cabot1.png 472 × 472; 78 KB
- Cabot2.jpg 394 × 394; 26 KB
- Crys0.png 472 × 472; 109 KB
- Crys1.png 472 × 472; 63 KB
- Crys1A.png 531 × 531; 76 KB
- Crys2.jpg 472 × 472; 27 KB
- Crys2B.jpg 472 × 472; 38 KB
- Crys3.jpg 472 × 472; 67 KB
- Crys4.jpg 472 × 472; 59 KB
- Crys5.jpg 472 × 472; 65 KB
- Crys6.jpg 472 × 472; 66 KB
- DLBCL.jpg 315 × 315; 41 KB
- DM1.png 472 × 472; 152 KB
- DM2.jpg 472 × 472; 43 KB
- DM2A.jpg 472 × 472; 51 KB
- DM3.jpg 957 × 941; 204 KB
- Double1.jpg 472 × 472; 30 KB
- Double2.jpg 472 × 472; 35 KB
- Double3.jpg 472 × 472; 28 KB
- Double4.jpg 472 × 472; 25 KB
- ET Hb metabolism-label.jpg 472 × 472; 148 KB
- ET Hb metabolism.jpg 472 × 472; 139 KB
- ET stage 1.jpg 472 × 472; 36 KB
- ET stage 1 title.jpg 472 × 472; 46 KB
- ET stage 1c.jpg 472 × 472; 173 KB
- ET stage 2.jpg 472 × 472; 48 KB
- ET stage 2 title.jpg 472 × 472; 47 KB
- ET stage 3.jpg 472 × 472; 72 KB
- ET stage 3 title.jpg 472 × 472; 49 KB
- Ec0.png 472 × 472; 91 KB
- Ec1.png 472 × 472; 106 KB
- Ec2.jpg 472 × 472; 32 KB
- Ec3.jpg 472 × 472; 53 KB
- Ec4.jpg 472 × 472; 53 KB
- Ec5.jpg 472 × 472; 49 KB